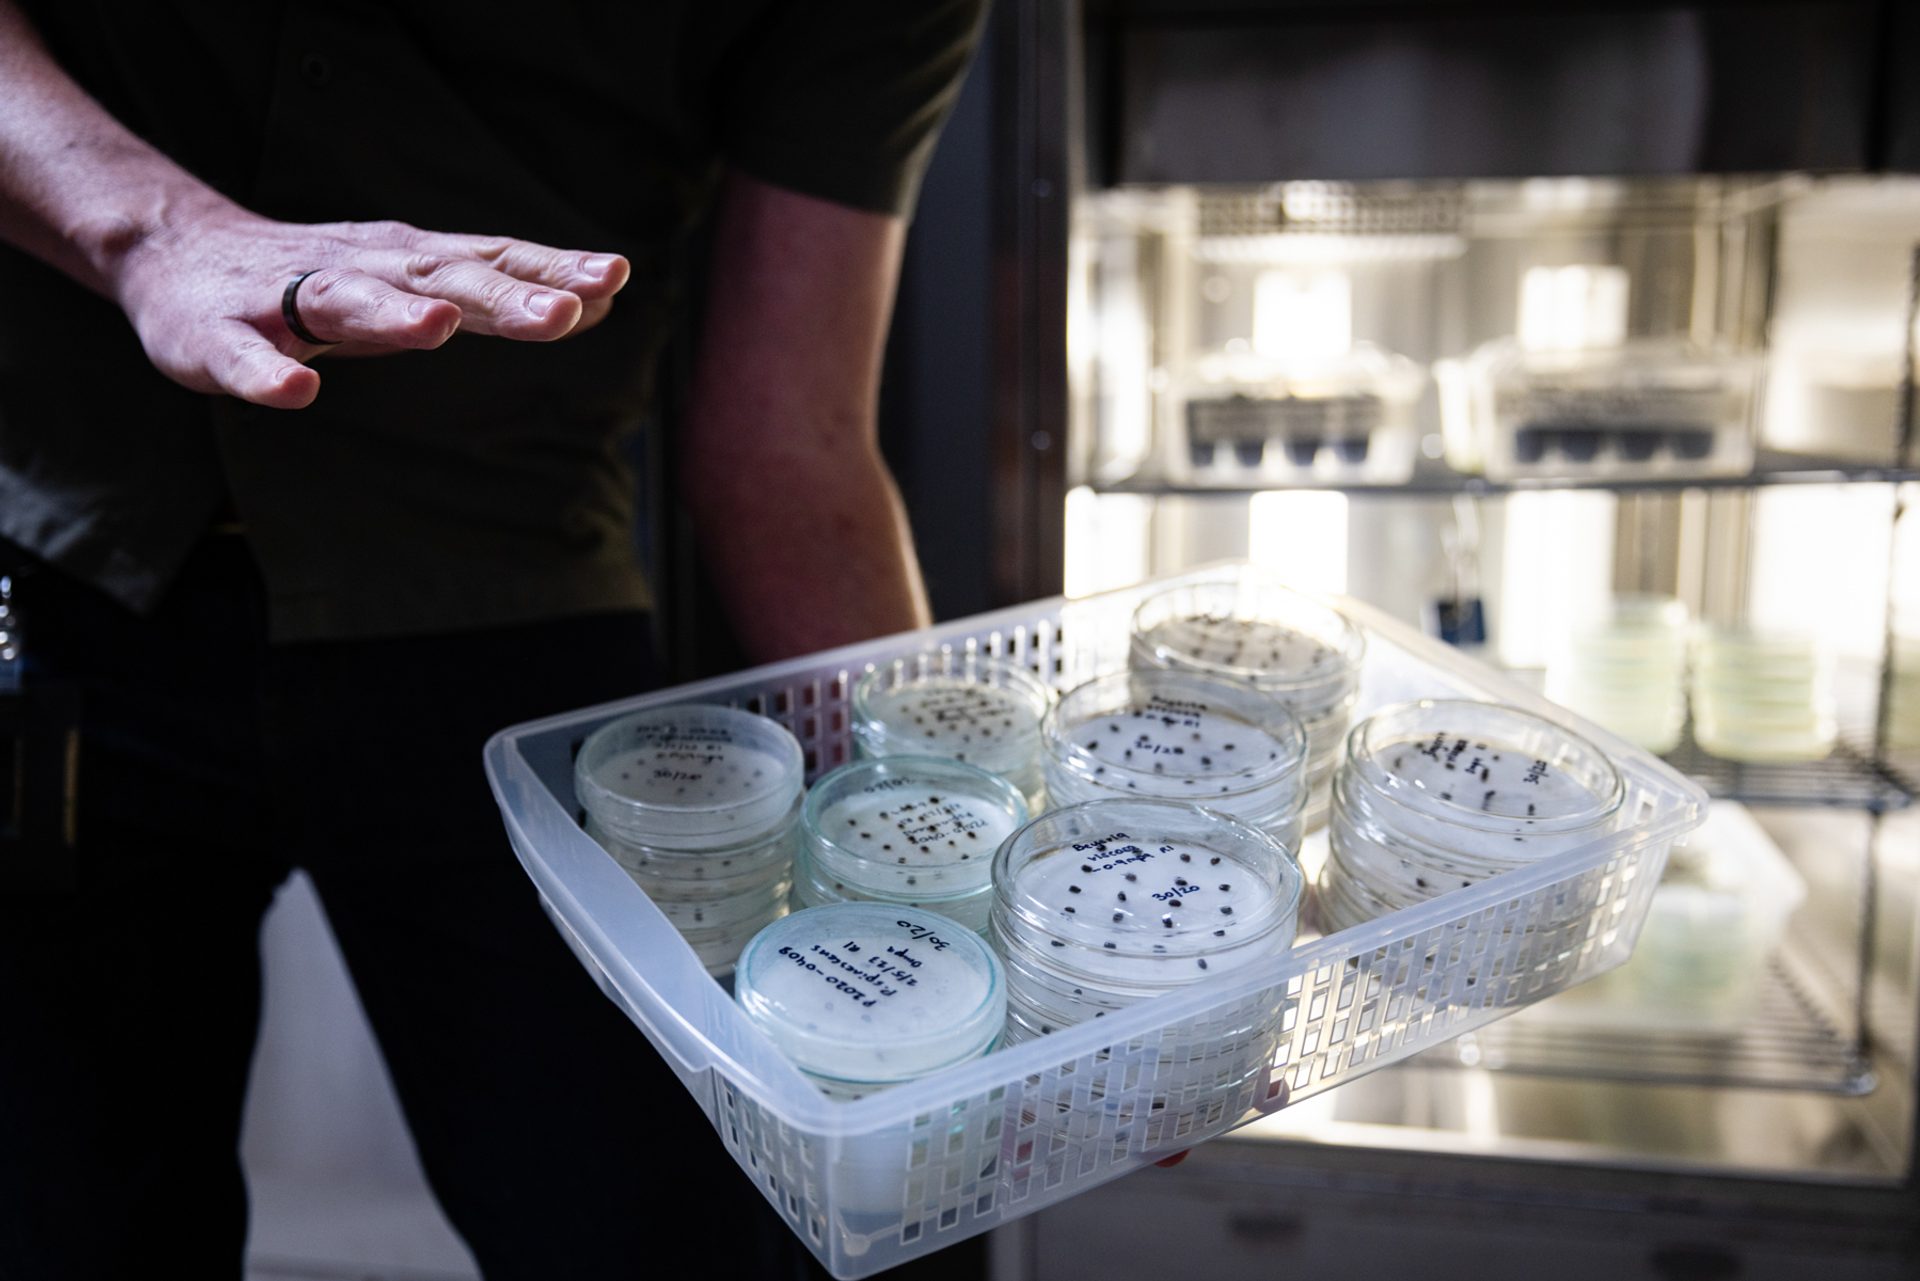
Hands presenting a basket of petri dishes at Australian PlantBank Tour

Sydney Design Week 2023 Recap

‘The 27th Sydney Design Week (2023) offered a platform to the critical research, industries, infrastructure and technologies that underpin design practice in our city, inviting plural perspectives from our local communities.’
Titled Amodern, in response to an essay by French philosopher Bruno Latour (1947–2022), the program enlisted six fields of enquiry: Eco Systems, Material Cultures, Communal Cities, Micro Cycles, Connected Threads and Photofields, to explore the complex and interconnected social and natural ecologies in which contemporary design operates.
Tour of Punchbowl Mosque
Architect Angelo Candalepas and designer Peter Gould hosted a tour of the award-winning Punchbowl Mosque, which unites concepts of religion, history and faith. This union is most evident in the main prayer space, which references ornamental ‘muqarnas’ in traditional Islamic architecture that illuminate the space throughout the day.
‘Architecture is one of the arts that can allow a 'universal’ understanding of emotional experience to form an epiphany.’

Material Ecologies Design Lab (MEDL) x Sydney Design Week kitchen
The University of Sydney Material Ecologies Design Lab co-presented a series of workshops and exhibits fusing art and sustainability in a pop-up studio near Central Station.
Thread, curated by Margaret Hwang, showcased experimental designers and artisans from across Asia-Pacific weaving new narratives for contemporary textile and sustainable design.
Melvin Josy displayed Hysteresis, a series of critical design objects made from recycled rubber crumbs, examining the material's evolution and its story from extraction to disposal and potential reuse.
The MEDL kitchen showcased designers Dr Stefan Lie, Nahum McLean, Saul Mazabow, Dr Kate Scardifield and Ella Williams, working with sustainable, renewable and bio-based materials, sparking conversation about material futures, circularity and design responsibility.

Writing Rooms at the Whitlam Prime Ministerial Home
Powerhouse invited expressions of interest from established, emerging and student practitioners interested in design writing to participate in an afternoon workshop held at the family home of Australia's 21st Prime Minister, the Hon Gough Whitlam AC QC.
The workshop was hosted by Sophie Lanigan, editor of Union Magazine, and Charles Rice, Fullbright Scholar and published author, and offered a productive and fun way for writers to explore design journalism and respond to the unique heritage setting of the Whitlam Prime Ministerial Home in Cabramatta.
Similar to a still life drawing class, the workshop included two writing sessions that encouraged participants to reflect on the home.

Workshop in Modest Fashion Design
A full day, intensive workshop was led by fashion designers and digital creatives exploring the innovation and beauty of contemporary modest fashion. Participants collaborated with industry leaders and emerging talent to explore contemporary design, cultural identity and sustainability. Led by Powerhouse, the program was fully subsidised for successful applicants.
Workshop leaders included digital creator and fashion influencer Nawal Sari, designer Anjilla Seddeqi, Powerhouse curator Glynis Jones, head of school at the TAFE NSW Fashion Design Studio (FDS) Laura Washington, founder of Fabrics of Multicultural Australia Sonia Gandhi, co-founder of Twiice Boutique Nigara Momin and photographer Zahrah Habibullah.

Tour of Australian Plantbank
The tour of the Australian PlantBank led by Peter Titmuss, architect and principal at BVN, and John Siemon, director of horticulture and living collections at the Botanic Gardens of Sydney, highlighted the unique design of the PlantBank and its science conservation programs.

Tour of Warragamba Dam
The 90-minute tour of Warragamba Dam was led by architect Annabel Lahz (Lahznimmo Architects), General Manager Regional Operations Sydney, Brian Mayhew (Water NSW) and catchment area manager Mary Knowles (Water NSW). It explored the Dam’s ground-breaking design and shared insights into Sydney’s complex water supply system.
Warragamba Dam is located 65 kilometres west of Sydney in a narrow gorge of the Warragamba River on the lands of the Gundungurra Nation.
More than a century after its location was first suggested, work commenced in 1948 to build a reliable new water supply for Sydney’s growing population. Completed in 1960, Warragamba Dam was constructed by 1800 workers of more than 25 nationalities using three million tonnes of concrete.
Lake Burragorang, the man-made reservoir formed behind Warragamba Dam, supplies up to 80 per cent of the water used by more than five million people living in Greater Sydney today. It is one of the world’s largest drinking water supply dams.